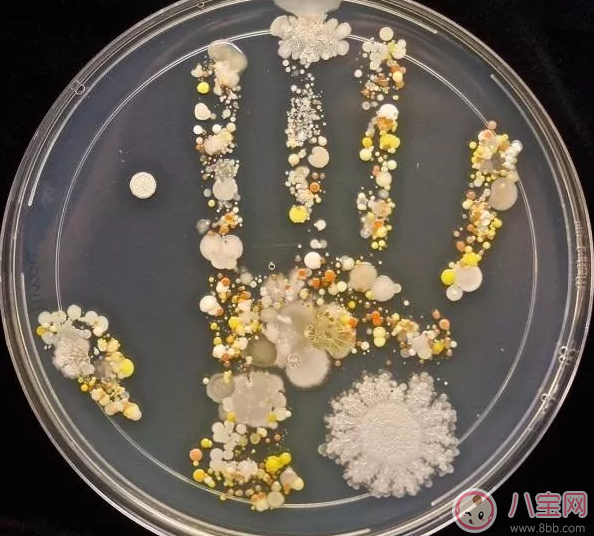
孩子不洗手的細菌多不多 因為不洗手而生病的概率大嗎

時間:2017-10-15 11:58:57來源:本站整理作者:wsl點擊:
今天是世界洗手日,不過可能很多的人都會覺得洗不洗手的差別都不是很大吧,所以在生活中會忽略洗手。其實這種想法是錯誤的。而且很多孩子在自己的生活中喜歡摸摸爬爬,手上的細菌超多的,那么孩子不洗手會因此生病嗎,孩子手上的細菌究竟有多少呢,八寶網小編為大家帶來孩子洗手的重要性。
這是美國的一位研究員,
將8歲兒子的手“印”在裝有果凍的餐盤上,
放到實驗室的孵化器內培養的
“小手細菌圖”。
我知道這一刻你一定想洗手!
今天是世界洗手日。
媽媽們一定想象不到:一只沒洗的手上,至少有4萬-40萬個細菌。而且孩子用沾了細菌和病原體的手,揉眼睛、摸鼻子,甚至吃手,就會同時把細菌帶入自己的身體。所謂感染就是如此了,整個過程可能只用幾秒,但引起的感染卻會持續數天、數周或更長時間。
每年,有超過350萬兒童因為腹瀉和肺炎不能迎來他們的5歲生日。然而,這些聽起來很恐怖的病,預防起來卻很簡單——
最直接有效的方式就是:勤洗手。
洗手的目的,就是去除這些細菌。

首先是,洗手的頻率不夠!通常我們要求寶寶在飯前、便后洗手,但是你知道嗎?洗手的密度恐怕最好遠遠高于這個頻率。吃飯前要洗手,包括吃零食;去完洗手間后要洗手;從外面玩回來的任何時候都要洗手;摸過外面動物或家里寵物后要洗手;打噴嚏后或者咳嗽后,當用手擋住嘴巴后,要記得洗手;當家里面有人生病了,記得要勤洗手……
其次是,洗手的時間不夠!美國兒科學會認為,保持摩擦和擦洗15至20秒,才能有效地去除細菌。
第三是,洗手的步驟不足!究竟怎么洗呢?解決媽媽問題,《洗手兒歌》來一發!這首洗手歌是一位有愛的幼兒園老師親自編噠~小朋友們都喜歡!別看稍微有點長,正好能滿足上面那條原則——洗夠15-20秒,媽媽們可以感受下,念完真心差不多!按這個洗手準沒錯!
卷起長袖子,漏出白胳膊。
打開水龍頭,沖沖水,
關掉水龍頭,抱起小肥皂,
123,放下小肥皂,
搓搓小手心,搓搓小手背,
手指插一插,兩個好友手拉手,
搓搓兩個大拇指,其他手指轉一轉,
最后記得小手腕,
打開水龍頭,沖掉小泡泡,
關掉水龍頭,謝謝水龍頭。
摘下小毛巾,漏出小笑臉,
小手擦干了,送回小毛巾。
拉下長袖子,小手變金鎖。
第四是,洗手的用品選錯了!僅僅用清水洗手,而不用肥皂或洗手液,效果會差很多。
然而肥皂、洗手液、免洗洗手液、濕紙巾……這么多種產品,究竟該選哪種好?
無論選擇哪種洗手的產品,只要是合格的產品,其實都是可以使用的。不過我們也理解媽媽的心,總希望給孩子最有效最安全的。所以如果硬要凹個順序,我們《父母世界Parents》測評委員會部經過認真的總結,認為或許你可以遵循這個順序:
洗手液>肥皂>免洗洗手液>濕紙巾
洗手液和肥皂都是咱們小朋友日常使用最多的產品,也是洗手最有效、除菌率最高的產品。它們從除菌的角度很難分伯仲。
很多年以前,肥皂均屬于皂類產品,偏堿性,當時人們認為對寶寶幼嫩的皮膚刺激性較大,不過如今隨著產品進一步精分和成熟,通常合格的寶寶產品,都不會有刺激的成分;
同理,之前認為,洗手液含有多種抗菌化學物質,有些液體過于黏稠,用后會使皮膚干燥起皮,不利于保護寶寶嬌嫩的皮膚,實際上,寶寶專用的洗手液在設計時充分考慮到了寶寶膚質嬌嫩的特點,在降低對皮膚的刺激的同時,還添加了一些滋潤、保濕的護膚成分,增加了對寶寶皮膚的保護。
那它們的區別在于哪里呢?
為什么說洗手液要比肥皂排在更優先的位置?
因為最近有一個實驗,研究人員曾經對不經常清洗的盛放肥皂和香皂的皂盒進行了檢測,檢測結果顯示其總細菌數不合格率高達70%~90%,而洗手液一次一滴的泵頭按壓式設計,有效避免了細菌滋生,同時,也更有效避免了交叉感染。寶寶使用會更安全。

德國Hipp喜寶洗臉洗手液
首先造型一定是孩子喜歡的!可愛小鴨子,有趣的鴨子大泵頭,輕輕一按押出豐富又細膩的泡沫,免敏無淚,洗手洗臉液兩用。

英國Squidsoap章魚寶寶洗手液
每次按壓洗手液時,手上就會被印上一個小印章(這種墨跡對兒童是絕對安全的)。接下來需要不斷地搓洗15-20秒以后印章才會消失,別小看這20秒,這一時間恰好是國際疾病預防中心推薦的洗手時間。
earth muse 自動感應泡沫洗手機

搭載紅外線感應器感應,不需要按壓,避免接觸交叉感染,所以特別推薦給新生寶寶或者幼兒園使用。有綠茶和西柚香型可選。
從成分來看,免洗洗手液產品主要分為兩類:
一類通常是成人使用,是以酒精為主要有效成分,大約50%-80%的酒精,加上20%左右的甘油;
另一類兒童使用更多,不含有酒精,但含有“含氯的消毒劑”比如苯扎氯銨作為主要成分,再加上中鏈甘油三酯、檸檬酸三乙酯等脂類,起到護膚作用。
不過,其實,“酒精”這樣的殺菌成分雖然對皮膚又刺激,但總體可以自行揮發掉,即使是沒有完全揮發掉的藥物成分(只要是符合國家質檢的正規品牌)也不會對皮膚或人體其他部分造成傷害;而免洗洗手液,里面含有的物質,比如苯扎氯銨會殘留在手上,被孩子大量誤食的話可能會產生不良影響。
愛吃手的小朋友,在使用免洗洗手液之后,一定要配合濕巾,而且容易過敏的小朋友更要慎用。
至于寶寶的濕巾,其實更多的是去除表面的污垢,比如泥土、食物的汁水等等,實際是沒有“殺菌”作用的。
所以最后提醒的一點是:在戶外給寶寶清潔小手,媽媽最好先用濕紙巾去除寶寶小手上的灰塵、泥土和其他污物,再用免洗洗手液給寶寶清洗雙手,這樣“去污”和“殺菌”效果會更理想。
Babyganics無香型兒童免洗洗手液

絕對是爆款中的爆款,美國兒童醫學院推薦產品。不含酒精,所有成分都來自天然,無毒無污染,清潔效果同樣讓人滿意,天然原料極易沖洗,生物分解,既健康又環保。富含2倍啫喱,提升滋潤度。放在媽媽的貼身包包里面,大小剛合適。
日本建榮制藥手美果免洗洗手啫喱

日亞排名第一,速干消毒殺菌的效果出眾。帶寶寶外出首選!外出用餐前、接觸玩具后、吃零食前、如廁后都可以使用,還有輕量便攜裝可供選擇,不會增加媽媽出行負擔的同時,又可以為寶寶抵擋住外來細菌的侵害哦!
日本paper soap兒童皂片

小小一盒可以隨身攜帶,一盒50片紙香皂可以用很久,薄薄的一片遇水就可以搓起很多泡泡,干凈衛生,隨時隨地,保持干凈衛生。6個月以上的寶寶就可以使用,外出攜帶炒雞方便哦~ 6種香型:玫瑰味/檸檬味/草莓味/薰衣草味/薄荷味/蘋果味。
網友跟帖
Copyright 2015-2020 8bb.com 〖八寶網〗 版權所有 鄂ICP備19016373號-1
聲明: 本站文章均來自互聯網,不代表本站觀點 如有異議 請與本站聯系 本站為非贏利性網站 不接受任何贊助和廣告
網友評論僅供其表達個人看法,并不表明八寶網立場。